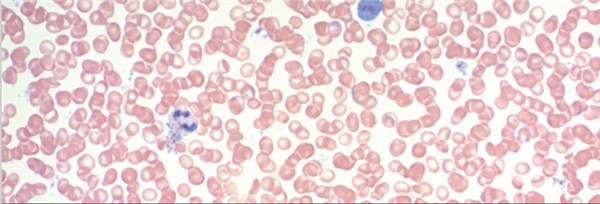
Giemsa-Stain-Kit.jpg
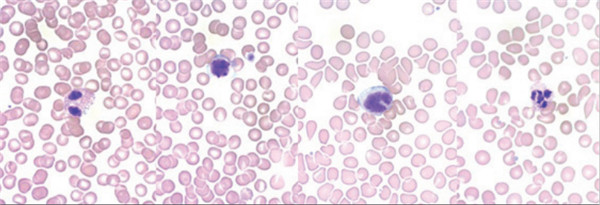
Quick-Dip-Differential-Stain-Kit.jpg

PRODUCT CENTER
特色產(chǎn)品當(dāng)前位置:首頁 > 特色產(chǎn)品
今時(shí)今日,已入數(shù)九之三九天,馬上四九了,所謂“熱在三伏,冷在四九”,一年中當(dāng)最寒冷的時(shí)期便是"三九、四九天"。難怪最近早上起來,看起來艷陽高照,但是冷氣沒有減少分毫。隨著天氣的轉(zhuǎn)冷,全國人民都在抗寒的同時(shí),也在抗擊新冠疫情,最近天天位居熱搜榜首的便是:本日新增本土確診病例xx例。正如幾個(gè)月前專家的預(yù)判,新冠病毒會(huì)在年冬寒冷時(shí)節(jié)再次襲來,所以呀,我們現(xiàn)在要做的就是要出門戴口罩,少聚集,勤洗手,多消毒,保護(hù)好自己,然后過個(gè)平安年。
最近很多學(xué)校應(yīng)該也放假了,想必很多同學(xué)也對我們老生常談的東西不感興趣。今天我給大家聊點(diǎn)新鮮事。那就是最近我們武漢艾美捷科技最近新談成了一個(gè)合作,新代理了一個(gè)品牌Scytek。這是一家比小編還要有年代感的公司,始建于1991年,生產(chǎn)多種優(yōu)質(zhì)試劑,不斷應(yīng)用于各種學(xué)科,包括免疫學(xué),組織學(xué),細(xì)胞學(xué),微生物學(xué)和血液學(xué)等。ScyTek公司的ELISA試劑包括顯色底物,結(jié)合物穩(wěn)定劑,封閉緩沖液,稀釋液和漂洗緩沖劑,免疫組織化學(xué)試劑包括SensiTek和UltraTek檢測系統(tǒng)以及單克隆和多克隆一抗,組織學(xué)試劑包括許多特殊染色試劑盒,常規(guī)染色試劑盒,固定劑,封片劑,漂洗緩沖液以及染色設(shè)備。今天我要給大家說說幾款檢測真菌、細(xì)菌、油門螺旋桿菌之類的額特殊染色試劑盒。
很多時(shí)候我們買一種指標(biāo)的染色試劑,它只能染這一種指標(biāo),我們需要購買多種試劑復(fù)染才能真正區(qū)分一個(gè)檢測玻片里到底都有些什么東西,尤其是要觀察細(xì)胞或者組織中的微生物的時(shí)候,我們要能很明顯的區(qū)分細(xì)胞或者組織與微生物之間的界限,這樣我們才能更好的判定這個(gè)微生物在宿主體內(nèi)的分布和活動(dòng)方式。我們的特殊染色試劑盒不需要您費(fèi)盡心思要買哪些試劑怎么配置,您只需要購買這一個(gè)試劑盒就可以解決您的問題,省時(shí)省力還方便實(shí)用!接下來我們看看具體的產(chǎn)品吧:
1.Cat# FLS-1,Fite’s Stain Kit (Leprosy & Nocardia Procedures)
組份:二甲苯-花生油溶液;Carbol品紅溶液;酸性酒精1%亞甲藍(lán)溶液
目的: Fite的染色工具包(用于麻風(fēng)病)旨在用于麻風(fēng)分枝桿菌(麻風(fēng)病)的組織學(xué)可視化。 麻風(fēng)桿菌和諾卡氏菌會(huì)染成紅色,而背景會(huì)染成藍(lán)色。該試劑盒里每個(gè)組份也都可以批量購買。
結(jié)果圖:

2.Cat#GMG-1 Giemsa Stain Kit (May-Grunwald)
組份:May-Grunwald溶液, Giemsa儲(chǔ)備溶液, 磷酸鹽緩沖液
目的:Giemsa染色試劑盒(May-Grunwald)專用于可視化造血組織和某些微生物中存在的細(xì)胞。 該試劑盒可用于福爾馬林固定石蠟包埋或冷凍切片。 核染成藍(lán)色/紫紅色。 細(xì)胞質(zhì)染成淡藍(lán)色; 膠原蛋白和肌肉纖維染成淡粉紅色; 紅細(xì)胞染成灰色,黃色或粉紅色; 立克次氏體染成紫紅色; 幽門螺桿菌染成藍(lán)色; 肥大細(xì)胞將深紅色顆粒染成深藍(lán)色。該試劑盒里每個(gè)組份也都可以批量購買
結(jié)果圖:
3.Cat#KAA-1 GMS Stain Kit
組份:硝酸銀溶液,甲胺硼砂溶液,氯化金溶液,淺綠色溶液,龍膽紫溶液,碘溶液,革蘭氏脫色劑,亞硫酸氫鈉溶液,氧化液,硫代硫酸鈉5%,紅色復(fù)染,酒石酸溶液
目的:改良的Gomori甲基六胺-硝酸銀染色劑(GMS染色試劑盒)旨在用于真菌,基底膜和某些機(jī)會(huì)性生物(如卡氏肺孢子蟲)的組織學(xué)可視化。 此外,該程序還將顯示放線菌和相關(guān)物種,諾卡氏小行星諾卡氏菌和某些包囊細(xì)菌。 鉻酸和危害較小的替代氧化劑均可使用。
結(jié)果圖:

4.Cat#AYH-1 H. Pylori Stain Kit
組份:高碘酸溶液,焦亞硫酸鈉溶液,阿爾西亞黃溶液,甲苯胺藍(lán)溶液,氫氧化鈉溶液
目的:H. Pylori染色試劑盒設(shè)計(jì)用于在福爾馬林固定的石蠟中演示幽門螺桿菌包埋組織。 甲苯胺藍(lán)將幽門螺桿菌染成深藍(lán)色,背景染成淺藍(lán)色。阿爾辛黃色將粘蛋白黃色染色,為藍(lán)色幽門螺桿菌提供了對比。
結(jié)果圖:

5.Cat# PASF-1 Periodic Acid Schiff (PAS) for Fungus Stain Kit
組分:高碘酸溶液 Schiff溶液 淺綠色溶液
目的:PAS真菌染色試劑盒旨在用于組織切片中真菌生物的組織學(xué)演示。 Schiff’s Solution將真菌生物和PAS陽性物質(zhì)染成洋紅色,然后淺綠色溶液將剩余的背景染色為綠色/藍(lán)色。
結(jié)果圖:

6.Cat# QDK1 Quick-Dip Differential Stain Kit
組分:Quick-Dip Fixative,Quick Dip Solution 1,Quick Dip Solution 2
目的:快速浸入式差異染色試劑盒提供了三種試劑,可對血涂片進(jìn)行快速染色。 甲醇用于快速修復(fù)涂片,然后用緩沖的x噸和噻嗪染料進(jìn)行差異染色。 Quick Dip Solution 2也已用作福爾馬林固定組織的簡單藍(lán)色染料,并用于鑒定細(xì)菌。 僅供研究使用。
結(jié)果圖:
7.Cat# SSK-1 Steiner Stain Kit (For Spirochetes)
組份:氧化劑溶液,福爾馬林鋅溶液,膠粘劑溶液,對苯二酚,硝酸銀溶液 0.2%,硝酸銀溶液1%
目的:展示真菌,幽門螺桿菌,嗜肺軍團(tuán)菌和螺旋藻感染組織的非常常見的銀染劑。 銀色污點(diǎn)螺旋體,幽門螺旋桿菌,真菌和軍團(tuán)菌呈黑色至棕色,同時(shí)還提供黃色至棕褐色的背景。 使用說明(IFU)中也提供了快速微波程序。
結(jié)果圖:

8.Cat# WSS-1 Warthin-Starry Stain Kit
組份:SpiroPrep,明膠溶液,硝酸銀溶液0.5%,對苯二酚溶液0.1%, 硝酸銀溶液2%
目的:Warthin-Starry染色試劑盒適用于螺旋體、幽門螺旋桿菌、嗜肺軍團(tuán)菌和貓抓傷熱細(xì)菌的可視化,所有這些細(xì)菌在20分鐘內(nèi)都會(huì)被染成深褐色至黑色。
結(jié)果圖:

各位小伙伴們要是對我們的新品牌Scytek感興趣的話,可以聯(lián)系小艾喲~~
作為一家具有高端的技術(shù)實(shí)力、先進(jìn)的經(jīng)營管理水平和完善的市場銷售體系的生物高科技企業(yè),總部位于武漢光谷高新技術(shù)開發(fā)區(qū),服務(wù)面向全國。艾美捷科技是集進(jìn)口試劑、實(shí)驗(yàn)室耗材銷售、技術(shù)服務(wù)與合約開發(fā)為一體的專業(yè)化高科技公司,為用戶提供專業(yè)的前沿資訊、完備的產(chǎn)品、整合的解決方案,及優(yōu)質(zhì)的物流服務(wù)。為了更好的服務(wù)客戶,公司組建了一支經(jīng)驗(yàn)豐富的研發(fā)團(tuán)隊(duì)-艾美捷生物技術(shù)中心,進(jìn)入研發(fā)生產(chǎn)階段,將更優(yōu)質(zhì)的產(chǎn)品推薦給國內(nèi)生物領(lǐng)域的同仁們!
艾美捷科技與國內(nèi)外優(yōu)秀的生物試劑供應(yīng)商優(yōu)保持著密切的合作關(guān)系,目前已成為眾多國際知名品牌的中國總代理或一級代理,主要包括:AmyJet、AAT Bioquest、Abnova、Agrisera、Abbexa、Biovision、Biosensis、Cayman Chemical、Caisson Labs、Cytoskeleton、CytoNiChe、Epigentek、Equitech-Bio、Hycult Biotech、ImmunoReagents、Jackson、LifeSensors、LigaTrap、Mabtech、Matreya、Norgen Biotek、Origene 、ProSpec、ProImmune、StressMarq、ScyTek 、SouthernBiotech、US Biological、Solis BioDyne等,可以在短時(shí)間內(nèi)為用戶提供專業(yè)的前沿資訊、完備的產(chǎn)品及物流服務(wù)。

微信掃碼在線客服